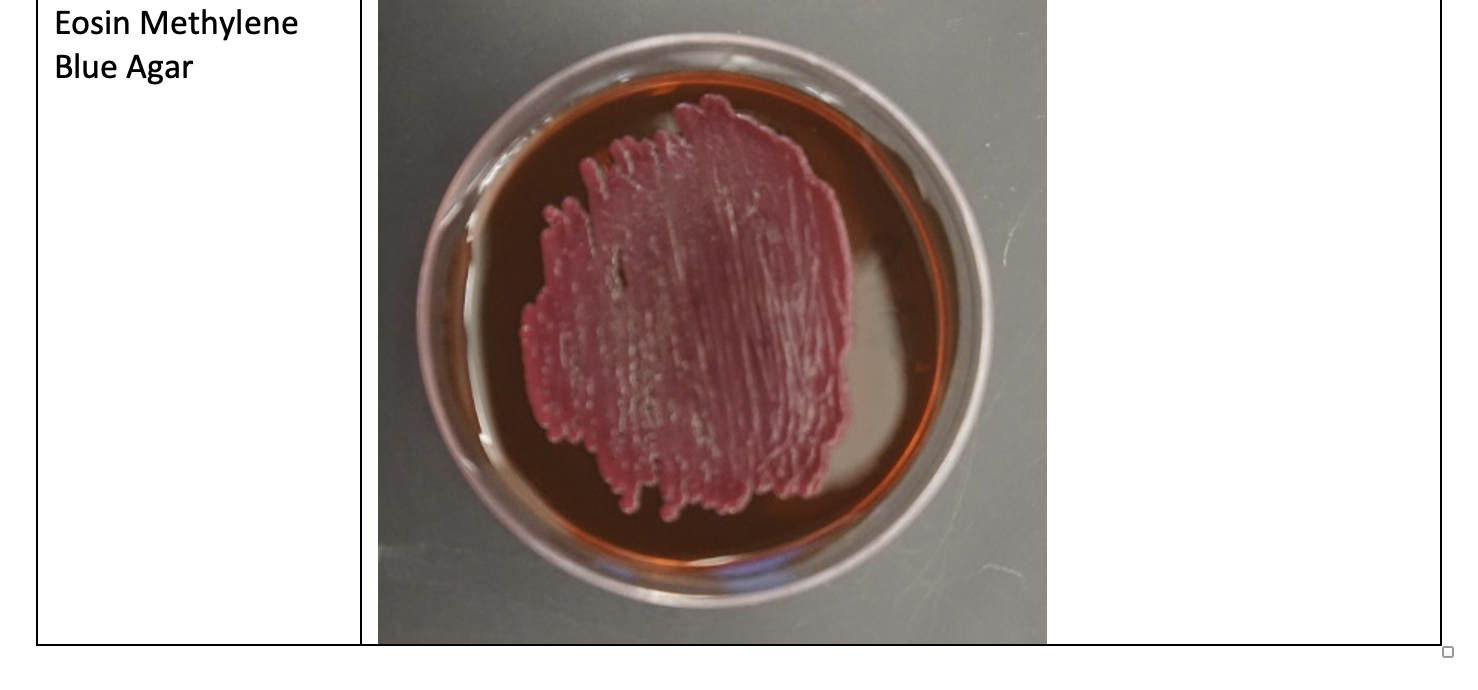
Solved I have to do a lab report about an unknown bacteria.

Descriptive Chart Unknown Bacteria
Descriptive Chart Unknown Bacteria. The "disadvantages" of a paper chart are often its greatest features in disguise. Things like naming your files logically, organizing your layers in a design file so a developer can easily use them, and writing a clear and concise email are not trivial administrative tasks. Fasten your seatbelt, ensuring the lap portion is snug and low across your hips and the shoulder portion lies flat across your chest. 58 Although it may seem like a tool reserved for the corporate world, a simplified version of a Gantt chart can be an incredibly powerful printable chart for managing personal projects, such as planning a wedding, renovating a room, or even training for a marathon.
Gallery Highlights

Microbiology Flowchart Unknown Bacteria amulette
25 Similarly, a habit tracker chart provides a clear visual record of consistency, creating motivational "streaks" that users are reluctant to break. The strategic use ...

Descriptive Chart Unknown Bacteria Quick Chart Maker
Can a chart be beautiful? And if so, what constitutes that beauty? For a purist like Edward Tufte, the beauty of a chart lies in ...

Solved Descriptive Chart Unknown MORPHOLOGICAL
It can take a cold, intimidating spreadsheet and transform it into a moment of insight, a compelling story, or even a piece of art that ...

Identification of Unknown Bacteria
This separation of the visual layout from the content itself is one of the most powerful ideas in modern web design, and it is the ...

Identifying Unknown Bacteria Lab DOCX
Patterns also offer a sense of predictability and familiarity. Parents can design a beautiful nursery on a modest budget.

Microbiology Flowchart Unknown Bacteria amulette
It cannot exist in a vacuum of abstract principles or aesthetic theories. 8 to 4.

Identifying Bacteria
The pressure in those first few months was immense. It is about making choices.

Microbiology Unknown Chart Ponasa
The typography is minimalist and elegant. It’s a return to the idea of the catalog as an edited collection, a rejection of the "everything store" ...

Identifying Unknown Bacteria Lab DOCX Chemistry Science
This perspective champions a kind of rational elegance, a beauty of pure utility. I had to research their histories, their personalities, and their technical performance.

Bacteria Flow Chart
The tools of the trade are equally varied. This phenomenon is closely related to what neuropsychologists call the "generation effect".

Unknown PDF Bacteria Biology
Additionally, digital platforms can facilitate the sharing of journal entries with others, fostering a sense of community and support. It is a discipline that operates ...

Solved Descriptive Chart Unknown MORPHOLOGICAL
In this extensive exploration, we delve into the origins of crochet, its evolution over the centuries, the techniques and tools involved, the myriad forms it ...

SOLUTION Bacteria identification flow chart docx Studypool
You could see the vacuum cleaner in action, you could watch the dress move on a walking model, you could see the tent being assembled. ...

Solved I have to do a lab report about an unknown bacteria.
102 In this hybrid model, the digital system can be thought of as the comprehensive "bank" where all information is stored, while the printable chart ...

Custom Writing Service www.fuste.pt
Instead of flipping through pages looking for a specific topic, you can use the search tool within your PDF reader to find any word or ...
Unknown bacteria identification
Carefully hinge the screen open from the left side, like a book, to expose the internal components. This system fundamentally shifted the balance of power.

Solved When scientific try to identify and unknown bacteria
A single smartphone is a node in a global network that touches upon geology, chemistry, engineering, economics, politics, sociology, and environmental science. Similarly, an industrial ...

Solved Idenitfy the unknown bacteria
I had to research their histories, their personalities, and their technical performance. Gently press down until it clicks into position.

How To Identify Unknown Bacteria Chart Ponasa
The engine will start, and the instrument panel will illuminate. It’s the disciplined practice of setting aside your own assumptions and biases to understand the ...

Unknown Bacteria r/microbiology
It is the visible peak of a massive, submerged iceberg, and we have spent our time exploring the vast and dangerous mass that lies beneath ...

Essential Flowchart for Identification of Unknown Bacteria
The object itself is often beautiful, printed on thick, matte paper with a tactile quality. By understanding the basics, choosing the right tools, developing observation ...

Identifying Unknown Bacteria Lab DOCX
20 This aligns perfectly with established goal-setting theory, which posits that goals are most motivating when they are clear, specific, and trackable. We are not ...

Solved Descriptive Chart Unknown MORPHOLOGICAL
Building Better Habits: The Personal Development ChartWhile a chart is excellent for organizing external tasks, its true potential is often realized when it is turned ...
Solved I have to do a lab report about an unknown bacteria.
And crucially, it was a dialogue that the catalog was listening to. The Tufte-an philosophy of stripping everything down to its bare essentials is incredibly ...

(Get Answer) Descriptive Chart STUDENT Habitat Unknown No. +12 LAB
To make it effective, it must be embedded within a narrative. This shirt: twelve dollars, plus three thousand liters of water, plus fifty grams of ...
The search bar became the central conversational interface between the user and the catalog. 37 The reward is no longer a sticker but the internal satisfaction derived from seeing a visually unbroken chain of success, which reinforces a positive self-identity—"I am the kind of person who exercises daily. This shift was championed by the brilliant American statistician John Tukey. Classroom decor, like alphabet banners and calendars, is also available. It means learning the principles of typography, color theory, composition, and usability not as a set of rigid rules, but as a language that allows you to articulate your reasoning and connect your creative choices directly to the project's goals. Business and Corporate Sector Lines and Shapes: Begin with simple exercises, such as drawing straight lines, curves, circles, and basic shapes like squares and triangles.